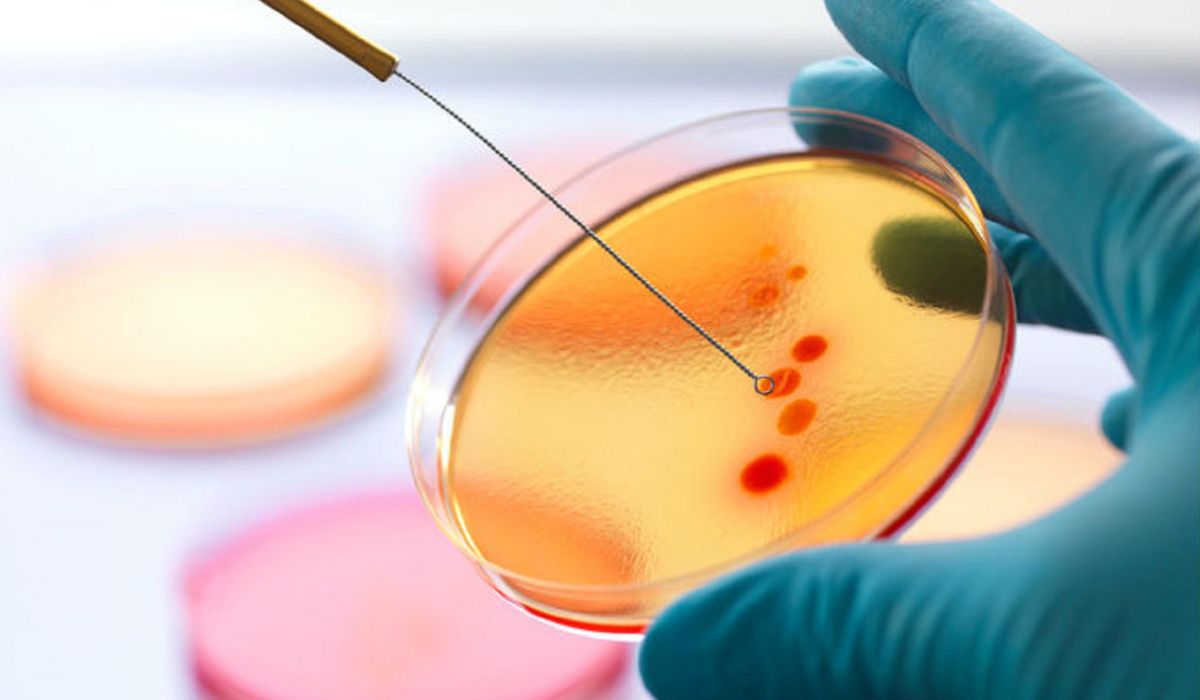
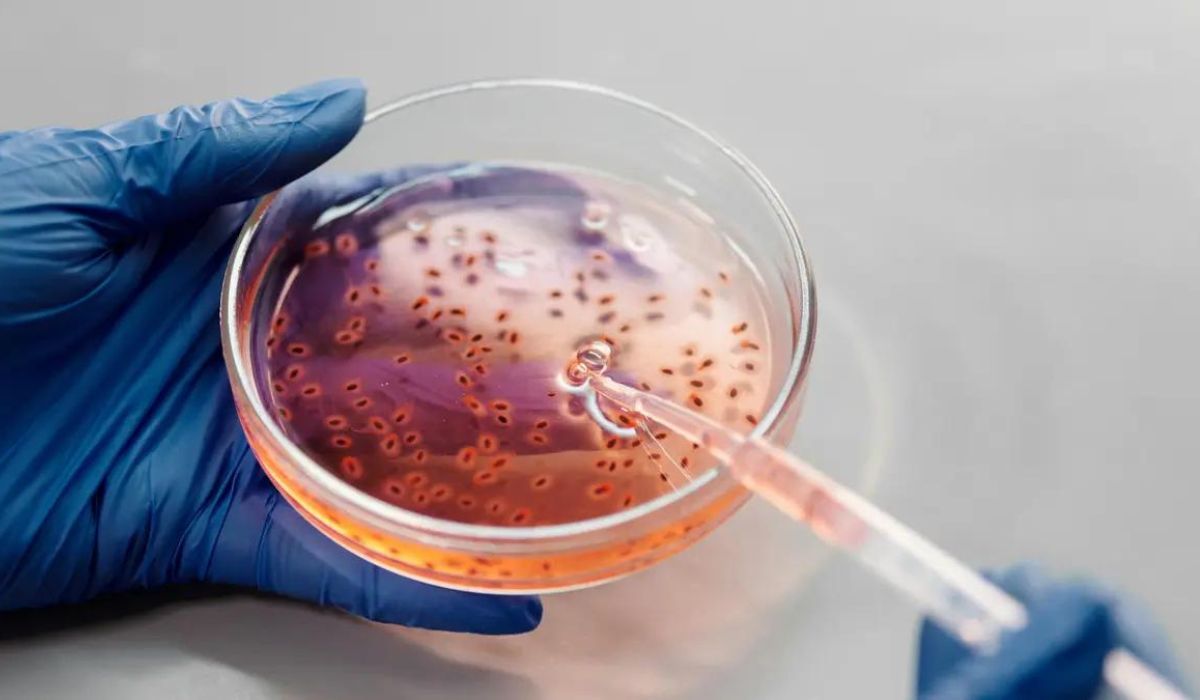

Pupuk pomi merupakan salah satu pupuk cair yang di buat dari bahan-bahan organik yang tentunya ramah lingkungan. Jenis pupuk ini di yakini bisa membantu tanaman tumbuh lebih baik. Menariknya lagi nih sahabat, pupuk ini juga mengandung mikroba pilihan yang sangat di butuhkan tanaman.
Namun agaknya, sekarang ini masih belum banyak yang tahu seperti apa penggunaan pupuk pomi yang tepat, bagaimana cara memilihnya, dan apa saja manfaat serta keunggulan dari pupuk ini. Itulah mengapa kali ini kami akan mengulas tuntas tentang pupuk pomi untuk para sahabat semua. Penasaran bagaimana selengkapnya? Yuk, Langsung simak informasinya berikut ini!
Cara Penggunaan Pupuk Pomi Pada Tanaman
 Untuk menggunakan pupuk pomi pada tanaman, tentunya sahabat perlu melakukannya dengan cara yang benar. Berikut langkah penggunaan pupuk cair pomi yang bisa sahabat coba:
Untuk menggunakan pupuk pomi pada tanaman, tentunya sahabat perlu melakukannya dengan cara yang benar. Berikut langkah penggunaan pupuk cair pomi yang bisa sahabat coba:
- Larutkan pupuk ke dalam air dengan perbandingan pupuk pomi 5ML : air 1L
- Semprotkan larutan pupuk ke tanah 1-2 hari sebelum penanaman
- Semprotkan kembali larutan pupuk pada batang daun dan akar tanaman setelah 15 hari usia tanam
- Untuk pemupukan lanjutan, pemberian pupuk bisa di lakukan setiap satu minggu sekali dengan menuangkan sekitar 300 ml larutan pupuk ke media tanam
- Lakukan penyemprotan dengan merata dan di arahkan ke permukaan daun bagian bawah
Oh ya! Jika sahabat menggunakan takaran tutup botol kemasan 1 liter, isinya setara dengan 10 cc atau 10ML. Sahabat juga bisa menggandakan dosis nya saat menyemprot bagian batang dan akar tanaman.
Cara Memilih Pupuk Pomi Terbaik Untuk Budidya yang Sukses
 Selain mengetahui cara penggunaan pupuk pomi yang baik untuk tanaman, sahabat juga perlu tahu nih bagaimana cara memilih pupuk cair pomi yang tepat. Jangan sampai salah memilih dan malah membuat tanaman tidak mendapatkan nutrisi yang di butuhkan. Berikut cara lengkapnya:
Selain mengetahui cara penggunaan pupuk pomi yang baik untuk tanaman, sahabat juga perlu tahu nih bagaimana cara memilih pupuk cair pomi yang tepat. Jangan sampai salah memilih dan malah membuat tanaman tidak mendapatkan nutrisi yang di butuhkan. Berikut cara lengkapnya:
Analisis Kebutuhan Tanaman
 Sama seperti halnya kita semua, setiap jenis tanaman pastinya punya kebutuhan nutrisi yang berbeda. Makanya pastikan pupuk yang di pilih mengandung unsur hara makro dan mikro yang sesuai dengan kebutuhan nutrisi tanaman.
Sama seperti halnya kita semua, setiap jenis tanaman pastinya punya kebutuhan nutrisi yang berbeda. Makanya pastikan pupuk yang di pilih mengandung unsur hara makro dan mikro yang sesuai dengan kebutuhan nutrisi tanaman.
Periksa Komposisi
 Selanjutnya sahabat perlu yang namanya memeriksa kandungan nutrisi pada pupuk cair pomi yang akan di beli. Periksa kandungan NPK, dan unsur mikro di dalamnya untuk memastikan bahwa pupuk memiliki kandungan yang sesuai.
Selanjutnya sahabat perlu yang namanya memeriksa kandungan nutrisi pada pupuk cair pomi yang akan di beli. Periksa kandungan NPK, dan unsur mikro di dalamnya untuk memastikan bahwa pupuk memiliki kandungan yang sesuai.
Pilih yang Memiliki Kandungan Mikroba
Sahabat juga perlu memilih pupuk pomi yang memiliki mikroorganisme bermanfaat bagi pertumbuhan tanaman. Ini bisa berupa nitrogen dan fosfat yang akan mendukung pertumbuhan tanaman.
Sahabat juga perlu memilih pupuk pomi yang memiliki mikroorganisme bermanfaat bagi pertumbuhan tanaman. Ini bisa berupa nitrogen dan fosfat yang akan mendukung pertumbuhan tanaman.
Periksa Ph Pupuk
 Pastikan ph pupuk yang di pilih sesuai dengan kebutuhan tanaman. Sebab jika sahabat memilih ph yang salah penyerapan nutrisi juga akan terganggu.
Pastikan ph pupuk yang di pilih sesuai dengan kebutuhan tanaman. Sebab jika sahabat memilih ph yang salah penyerapan nutrisi juga akan terganggu.
Periksa Harga
 Jangan lupa juga untuk mempertimbangkan harga dari pupuk yang akan di beli. Pastikan harganya sesuai dengan modal awal budidaya yang di lakukan.
Jangan lupa juga untuk mempertimbangkan harga dari pupuk yang akan di beli. Pastikan harganya sesuai dengan modal awal budidaya yang di lakukan.
Manfaat Pupuk Pomi Bagi Perkembangan Tanaman
 Bukan hanya praktis di gunakan, tapi ternyata pupuk ini juga memiliki ragam manfaat yang baik untuk tanaman, lho! Apa saja ya? Berikut adalah beberapa di antaranya:
Bukan hanya praktis di gunakan, tapi ternyata pupuk ini juga memiliki ragam manfaat yang baik untuk tanaman, lho! Apa saja ya? Berikut adalah beberapa di antaranya:
- Cocok untuk semua jenis tanaman
- Memberikan unsur hara makro dan mikro yang seimbang
- Menguraikan unsur P, K, S, dan Fe di dalam tanah dan membantu mengikat unsur hara N dari udara
- Mengandung mikroorganisme yang menghambat penuaan pada tanaman sehingga tanaman tidak cepat mati
- Meningkatkan kesuburan media tanam
- Membantu proses dekomposisi bahan organik dalam tanah
- Meningkatkan daya tahan tanaman terhadap serangan hama dan penyakit
- Menghemat penggunaan pupuk kimia hingga 50%
- Harganya terjangkau sehingga bisa mengurangi biaya produksi
- Tidak mengandung racun yang berbahaya bagi lingkungan
Keunggulan Pupuk Pomi Dibandingkan Pupuk Lain
 Nyatanya pupuk cair ini memiliki beberapa keunggulan yang membuatnya jadi pilihan pertama para petani. Berikut adalah keunggulan pupuk jenis ini di bandingkan pupuk lainnya:
Nyatanya pupuk cair ini memiliki beberapa keunggulan yang membuatnya jadi pilihan pertama para petani. Berikut adalah keunggulan pupuk jenis ini di bandingkan pupuk lainnya:
Kandungan C Organik yang Tinggi
 Pupuk pomi memiliki C Organik yang tinggi, lho! Yaitu sebesar 15%, yang akan membantu meningkatkan kesuburan tanah dan memberikan nutrisi penting bagi tanaman.
Pupuk pomi memiliki C Organik yang tinggi, lho! Yaitu sebesar 15%, yang akan membantu meningkatkan kesuburan tanah dan memberikan nutrisi penting bagi tanaman.
Memiliki Ph Ideal
 Jenis pupuk ini memiliki ph 4,5 yang cocok untuk kebanyakan jenis tanaman, terutama tanaman yang berbuah. Dengan ph yang ideal ini, pomi akan membantu penyerapan nutrisi jadi lebih baik lagi.
Jenis pupuk ini memiliki ph 4,5 yang cocok untuk kebanyakan jenis tanaman, terutama tanaman yang berbuah. Dengan ph yang ideal ini, pomi akan membantu penyerapan nutrisi jadi lebih baik lagi.
Mengandung Mikroba Unggulan
Pupuk ini di perkaya dengan mikroba pilihan termasuk Bacillus sp., Lactobacillus sp., Saccharomyces sp., Streptomyces sp., Pseudomonas sp., Azospirillum sp., Azotobacter sp., dan Rhizobium sp. Dimana semua mikroba ini berfungsi penting dalam memproduksi zat pengatur tumbuh.
Pupuk ini di perkaya dengan mikroba pilihan termasuk Bacillus sp., Lactobacillus sp., Saccharomyces sp., Streptomyces sp., Pseudomonas sp., Azospirillum sp., Azotobacter sp., dan Rhizobium sp. Dimana semua mikroba ini berfungsi penting dalam memproduksi zat pengatur tumbuh.
Meningkatkan Produksi Tanaman
 Pupuk cair jenis ini juga di yakini bisa meningkatkan produksi tanaman, termasuk mengurangi risiko gugur bunga dan buah. Selain itu pupuk ini juga berfungsi sebagai katalisator dalam penyerapan unsur hara tanaman.
Pupuk cair jenis ini juga di yakini bisa meningkatkan produksi tanaman, termasuk mengurangi risiko gugur bunga dan buah. Selain itu pupuk ini juga berfungsi sebagai katalisator dalam penyerapan unsur hara tanaman.
Bagaimana? Sudah tahu bukan bagaimana cara penggunaan, cara memilih, manfaat hingga keunggulan dari pupuk pomi ini? Nah, jika sahabat semua mau tahu informasi lebih lanjut, maka bisa mengunjungi akun youtube “Henry Tani”. Semoga bermanfaat!





